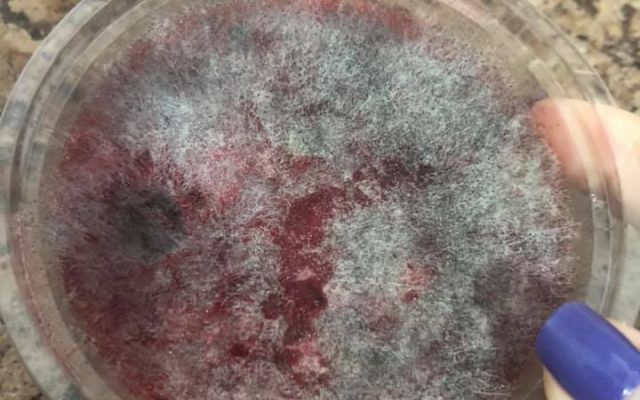
Українка купила в супермаркеті ласощі: всередині вона виявила огидний сюрприз

Українка купила в супермаркеті ласощі: всередині вона виявила огидний сюрприз
Колаж РБК-Україна: у Херсоні жінка купила желе з сюрпризом
У Херсоні жінка вирішила поласувати і купила желе. Але всередині солодощів її чекав огидний сюрприз. Все желе було вкрите пліснявою.
Про це повідомляє місцеве видання "Типовий Херсон".
Термін придатності, зазначений на продукті, був цілком прийнятний. Там вказувалося, що желе зробили два дні тому. Чому воно продавалося в такому вигляді - невідомо.
Користувачі під публікацією припускають, що, швидше за все, співробітники супермаркету просто перебивають дату випуску, тим самим продовжуючи життя вже зіпсованого товару.
Також українці відзначили, що тільки сліпий міг не помітити під прозорою кришкою цвіль, тому не можна звинувачувати супермаркет.
У Херсоні жінка купила желе з сюрпризом (фото: t.ks.ua)
Як ми писали раніше, у Кривому Розі жінка купила пакет гречки і виявила там гризуна. В пакеті з крупою перебувала мертва миша.